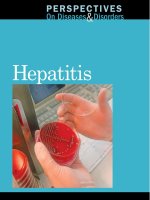
Perspectives on Diseases and Disorders Hepatitis pdf

Perspectives on Complementary and Alternative Medicine pot
Bạn đang xem bản rút gọn của tài liệu. Xem và tải ngay bản đầy đủ của tài liệu tại đây (9.48 MB, 421 trang )
Perspectives on Complementary and
Alternative Medicine
This book forms part of the core text for the Open University course K221 Perspectives
on Complementary and Alternative Medicine and is related to other materials available to
students, including two more texts also published by Routledge, Taylor & Francis:
■ Complementary and Alternative Medicine: Structures and Safeguards (Book 2)
■ Perspectives on Complementary and Alternative Medicine (Course Reader).
If you are interested in studying this course, or related courses, please write to the
Information Officer, School of Health and Social Welfare, The Open University, Walton
Hall, Milton Keynes MK7 6AA, UK.
Details are also given on the web page at
Perspectives on Complementary
and Alternative Medicine
Edited by Tom Heller, Geraldine Lee-Treweek,
Jeanne Katz, Julie Stone and Sue Spurr (The
Open University)
Routledge
Taylor & Francis Group
in association with
This book forms part of an Open University course K221 Perspectives on Complementary and
Alternative Medicine. Details of this and other Open University courses can be obtained from the
Course Information and Advice Centre, PO Box 724, The Open University, Milton Keynes MK7
6ZS, United Kingdom: tel. +44 (0)1908 653231; e-mail
Alternatively, you may visit the Open University website at where you can
learn more about the wide range of courses and packs offered at all levels by The Open University.
To purchase this publication or other components of Open University courses, contact Open
University Worldwide Ltd, The Open University, Walton Hall, Milton Keynes MK7 6AA, United
Kingdom: tel. +44 (0)1908 858785; fax +44 (0)1908 858787; e-mail ; website
First published 2005 by Routledge, Taylor & Francis 2 Park Square, Milton Park, Abingdon OX
14 4RN, United Kingdom
This edition published in the Taylor & Francis e-Library, 2006.
To purchase your own copy of this or any of Taylor & Francis or Routledge’s collection of
thousands of eBooks please go to
Copyright © 2005 The Open University
All rights reserved. No part of this publication may be reproduced, stored in a retrieval system,
transmitted or utilised in any form or by any means, electronic, mechanical, photocopying,
recording or otherwise, without written permission from the publisher or a licence from the
Copyright Licensing Agency Ltd. Details of such licences (for reprographic reproduction) may be
obtained from the Copyright Licensing Agency Ltd of 90 Tottenham Court Road, London W1T
4LP.
ISBN 0-203-02329-3 Master e-book ISBN
ISBN 0-415-351-60X (hbk)
ISBN 0-415-351-618 (pbk)
1.1
258590B/k221b1prelimsi1.1
Contents
Contributors
vi
Acknowledgements
viii
Introduction
x
Part 1 Complementary and Alternative Medicine in Context
1
Chapter 1
Changing perspectives
Geraldine Lee-Treweek
3
Chapter 2
Can complementary and alternative medicine be classified?
Julie Stone and Jeanne Katz
29
Chapter 3
Political and historical perspectives
Mike Saks
53
Chapter 4
Ethics in complementary and alternative medicine
Julie Stone
74
Chapter 5
Complementary and alternative medicine and mental health
Tom Heller
99
Part 2 People and Complementary and Alternative Medicine
126
Chapter 6
Understanding health and healing
Julie Stone and Jeanne Katz
128
Chapter 7
Understanding why people use complementary and alternative
medicine
Sarah Cant
155
Chapter 8
The therapeutic relationship and complementary and alternative
medicine
Julie Stone and Jeanne Katz
183
Chapter 9
Critical issues in the therapeutic relationship
Geraldine Lee-Treweek and Julie Stone
206
Chapter
10
CAM in supportive and palliative cancer care
Jeanne Katz
230
Part 3 Complementary and Alternative Medicine in Different Settings
259
Chapter
11
Traditional, folk and cultural perspectives of CAM
Andrew Vickers and Tom Heller
261
Chapter
12
Investigating patterns of provision and use of CAM
Andrew Vickers, Tom Heller and Julie Stone
289
Chapter
13
Cash and CAM: the private sector and CAM practice
Julie Stone and Tom Heller
313
Chapter
14
Integration of CAM with mainstream services
Tom Heller
336
Chapter
15
Information sources and complementary and alternative medicine
Tom Heller and Julie Stone
364
Index
384
Contributors
Tom Heller is a general practitioner in a deprived area of Sheffield. His practice is
associated with the integration of complementary and alternative forms of practice
alongside orthodox medical approaches. For the last 20 years he has also been a Senior
Lecturer at The Open University School of Health and Social Welfare and involved in
the production of a series of health-related courses.
Geraldine Lee-Treweek is a sociologist of health and illness and was a Lecturer in
Health Studies at The Open University until autumn 2004. Her main field of
specialism is complementary and unorthodox healing, in particular CAM therapeutic
relationships, the experience of long-term users of CAM and the professionalisation of
modalities. She also has long-standing interests in chronic illness and disability, trust
and belief in contemporary society, social gerontology and the sociology of
unexplained phenomena.
Jeanne Samson Katz is Director of Postgraduate Studies and a Senior Lecturer in the
School of Health and Social Welfare at The Open University. She is a medical
sociologist and has contributed to many courses in the health curriculum in the School
since 1990. Much of her research has focused on the care of people dying in different
settings, most recently in residential and nursing homes.
Julie Stone is Deputy Director of the Council for Healthcare Regulatory Excellence. She
was previously a lecturer in health care ethics and law, teaching pre- and post-
registration health care practitioners across a wide range of conventional and CAM
professions. A lawyer by training, Julie has advised many CAM bodies on ethical and
legal responsibilities and has contributed to policy initiatives in the CAM arena both
nationally and internationally. Julie has written and lectured extensively on legal,
ethical and regulatory aspects of complementary and alternative medicine. Her books
include: Complementary Medicine and the Law (1996, Oxford University Press) with
Joan Matthews; An Ethical Framework for Complementary and Alternative Therapists
(2002, Routledge); and Psychotherapy and the Law (2004, Whurr) with Peter Jenkins
and Vincent Keter.
Sue Spurr is a Course Manager at The Open University School of Health and Social
Welfare, working on health-related courses. She is a qualified teacher of science and
biology and is currently training to become a shiatsu practitioner.
Professor Mike Saks is Pro Vice Chancellor at the University of Lincoln. He was
formerly Dean of the Faculty of Health and Community Studies at De Montfort
University. He has published extensively on professionalisation, health care and
complementary and alternative medicine and given many presentations at national and
international conferences. His latest books include Regulating the Health Professions,
Complementary Medicine: Challenge and Change and Orthodox and Alternative
Medicine: Professionalization, Politics and Health Care. He has been a member and
chair of numerous NHS committees and has served on a range of national groups on
complementary and alternative medicine, including the NHS research and
development capacity building committee for this area. He is a member of the
Executive of the International Sociological Association Research Committee on
Professional Groups and the editorial team for the new international journal
Knowledge, Work and Society, as well as the current Chair of the Research Council for
Complementary Medicine.
Sarah Cant is Senior Lecturer in Applied Social Sciences at Canterbury Christ Church
University College. She has written extensively on the sociology of complementary
medicine and is currently researching the use of and access to complementary
medicine on the internet as well as continuing her interest in professionalisation.
Andrew Vickers is a research methodologist and statistician who has focused on
complementary and alternative medicine for much of his career. He received his
Bachelor’s degree in the History and Philosophy of Science from the University of
Cambridge and his doctorate in Clinical Medicine from the University of Oxford. He
has been an investigator on numerous clinical trials and systematic reviews of
complementary therapies, including a study of acupuncture for headache that is among
the largest randomised trials of acupuncture ever conducted. He has also conducted
considerable statistical and methodological research, with a particular emphasis on
randomised trials with quality-of-life outcomes. Dr Vickers now works at Memorial
Sloan-Kettering Cancer Center in New York where he has appointments in the
Departments of Medicine, Biostatistics, Urology and Public Health (Weill Cornell
Medical College). Dr Vickers’ most recent methodological research has centred on
medical prediction.
Acknowledgements
Grateful acknowledgement is made to the following sources for permission to reproduce
material in this book.
Chapter 1
Figure
Figure 1.1: Reproduced by permission of CPPIH.
Photographs
p. 12: Nigel Stead, LSE; p. 16, left: The Wellcome Trust; p. 16, right: unknown
source.
Chapter 2
Photographs
p. 40: The Wellcome Trust; p. 50: Anthea Sieveking/The Wellcome Trust.
Chapter 3
Photographs
pp. 61, 67 and 70: The Wellcome Trust; p. 73: Rex Features.
Chapter 5
Photographs
p. 112: Photographer Terry Di Paolo; p. 113: Hulton Archive; p. 120: Susan Tyler
Hitchcock, www.mdx.ac.uk/www/study/ylamb.htm; p. 128: Bernhard/Fotex/Rex
Features; p. 131: The Wellcome Trust.
Chapter 6
Photographs
p. 153: Sally and Richard Greenhill; p. 161: Science Photo Library.
Chapter 7
Photographs
p. 174: Wellcome Library, London; p. 191: Maximilian Stock Ltd/Science Photo
Library.
Tables
Table 7.1: Thomas, K.J., Nicholl, J.P. and Coleman, P. (2001) ‘Use and expenditure
on complementary medicine in England: population based survey’, Complementary
Therapies in Medicine, Vol. 9, Harcourt Publishers Ltd; Table 7.2: Ernst, E. and White,
A. (2000) The BBC survey of complementary medicine use in the UK’, Complementary
Therapies in Medicine, Vol. 8, Harcourt Publishers Ltd.
Chapter 8
Photograph
p. 210: BSIP Keene/Science Photo Library.
Chapter 9
Photographs
p. 243: Courtesy of Hay House, Inc.; p. 250: The Wellcome Trust.
Chapter 10
Photographs
p. 272: St Christopher’s Hospice; p. 276: Photograph courtesy of Marie Curie Cancer
Centre; p. 281: From Love, Medicine and Miracles by Bernie S.Siegel, MD, Arrow
Books; p. 282: Reprinted by permission of SLL/Sterling Lord Literistic, Inc. A/A/F
Bernard Siegel.
Figures
Figure 10.1: Payne, S., Seymour, J. and Ingleton, C. (eds) (2004) Palliative Care
Nursing, Open University Press; Figure 10.2: Barraclough, J. (ed.) (2001) Integrated
Cancer Care. Copyright © Oxford University Press.
Chapter 11
Photographs
p. 295: Courtesy of Center for Adventist Research, James White Library, Andrews
University; p. 298: Courtesy of Matt Utting; p. 301: Courtesy of J.D.Lasica; pp. 303 and
304: Science Photo Library.
Text
Box 11.11: R.Carroll (2003) ‘It’s green, prickly and sour, but this plant could cure
obesity and save an ancient way of life’, The Guardian, 4 January.
Chapter 12
Photographs
p. 336: Banana Stock/Alamy; p. 342: Courtesy of South Hams Tourism; p. 345:
Copyright © The Guardian.
Chapter 13
Photographs
p. 356: Science Photo Library; p. 369: Material reproduced with kind permission of
the Publisher, How To Books Ltd; p. 371: Today’s Therapist, Issue 25,
Chapter 14
Photographs
p. 382: Sally and Richard Greenhill; p. 386: Wellcome Library London; p. 391:
Alamy; p. 394: Dr Amita Raja, Homoeopathic Physician at the Royal London
Homoeopathic Hospital (Complementary Medicine on the NHS); p. 397: Science Photo
Library; p. 402: Photo courtesy of Mid Somerset Newspapers.
Figures
Figure 14.1: House of Lords Science and Technology Committee Sixth Report.
© Crown copyright material is reproduced under Class Licence Number
C01W0000065 with the permission of the Controller of HMSO and the Queen’s Printer
for Scotland.
Chapter 15
Photograph
p. 411: Science Photo Library.
Front cover
Photograph
Copyright © Getty Images
Introduction
The title Perspectives on Complementary and Alternative Medicine was chosen for this
book to reflect the need for a critical overview of the subject areas that relate to the
development of complementary and alternative medicine (CAM) as part of a dynamic
process of change in contemporary society. The recent changes and developments in and
the exponential growth of CAM are explored from a wide range of perspectives and
covering several academic disciplines. This book represents a collaborative process
among many academic disciplines and is designed to help you to understand and
contextualise the phenomenon of contemporary CAM. Political, historical, ethical,
geographical and economic perspectives are drawn on throughout this book in the search
for understanding.
Sociologists such as Anthony Giddens (1991) claim that the key drivers leading to the
growth of interest in CAM as part of a more general social change in ‘late modernity’
include: a more assertive consumer; a more accepting audience of a greater diversity of
ideas and sets of knowledge; and an increase in the number and range of people having
the confidence to set themselves up as ‘new experts’ in their field. A further significant
force that is integral to understanding the development of CAM is the political and
historical dimension. The history of CAM cannot be dissociated from that of orthodox
medicine. Before the Medical Registration Act 1858, when state-supported biomedicine
emerged and became protected as the dominant discipline, herbalists, healers and many
others, including lay people known as ‘wise women’ or ‘cunning men’, competed with
the same level of status as physicians, surgeons and apothecaries (Cant and Sharma,
1999). When orthodox medicine was established on a formal national basis in the mid-
19th century, the realm of CAM came into being by exclusion (Saks, 1992).
Is there a single entity called ‘complementary and alternative medicine’? Some
commentators such as Ursula Sharma (1992) argue that CAM represents such a broad
range of practices that have so little in common with one another that it is very difficult to
talk of them as a whole. This book explores and examines many different definitions of
CAM. A rationale is developed for considering CAM as a fluid description, which
changes according to dynamic processes internal to both the CAM movement itself and
its relationship with orthodox medical practice and other wider features of contemporary
society.
In general terms, health-related behaviours are determined by a highly complex
variety of influences. What motivates people to turn to CAM and what are they are
seeking from CAM? A huge range of CAM therapies are available, with differing
philosophies, claims and treatments. Most CAM remains in the private sector,
unsupported by the National Health Service (NHS) and requiring some financial
investment from the individuals seeking help. This financial constraint certainly prohibits
many people from using CAM. An examination of how many people use CAM and of
their sociodemographic profile highlights some of the current inequities associated with
CAM use, but it also offers some insights into the reasons why people step outside the
biomedical realm. Although users can access CAM for a variety of reasons and
conditions, in the UK, patients tend to see their biomedical practitioner (usually a general
practitioner or GP) before seeking care from a CAM practitioner, and they rarely abandon
biomedical care completely (Sharma, 1992; Thomas et al., 1991).
Historical perspectives demonstrate that the politicised marginalisation of CAM in the
UK reached a low point by the mid-20th century. Bakx (1991) describes this period as an
‘eclipse’ in which biomedicine became pre-eminent in the field of health and healing
post-industrialisation, temporarily eclipsing other forms of health work. Consumers’ and
practitioners’ interest in CAM grew dramatically since then, after the emergence of a
strong counter-culture that led to a CAM renaissance. This development increased the
political support for, and legitimacy of, several types of CAM therapy. The social and
cultural process underpinning this shift stems from changing ideas about health and
illness, and changing ideas about what doctors can and should deliver. People are taking a
much more active and critical role as consumers of health care and are increasingly
sceptical about the value of science (Giddens, 1991) and orthodox medicine in particular
(Gabe et al., 1994). However, as Giddens (1991) suggests, these changes are not simply
related to scepticism about biomedical knowledge: they also relate to lifestyle choices
and the search for alternative experiences that CAM might offer.
This interest, in turn, prompted the growing incorporation of some forms of CAM into
orthodox medicine. In many ways the report by the British Medical Association (BMA,
1993) can be considered a watershed in that it included the argument that an awareness of
CAM should be part of basic education for students of medicine and other health
professions. This does not mean that there is not considerable resistance to medicalisation
and incorporation from within the ranks of CAM. In particular, for some groups of CAM
practitioners, the growth of ‘integrative medicine’ represents an undermining of counter-
cultural values, as more holistic paradigms based on challenging orthodox biomedical or
‘scientific’ theories may become displaced through proximity to the dominant biomedical
systems.
This book explores the challenge for CAM practitioners in their attempt to gain
legitimacy through acting ethically and responsibly. Ethical practice requires the
application of appropriate knowledge, skills and attitudes, including the consideration of
users’ rights and values, being non-judgemental, developing listening skills and
delivering culturally sensitive care. All of these attributes, in addition to the knowledge
base, need to be acquired during the process of professional training and/or
apprenticeships for CAM therapists, as well as for those wishing to practise more
orthodox forms of health care. They are every bit as important as practitioners’ technical
skills. To be a ‘good’ practitioner requires both technical skills and ethical awareness.
It is hard to define or describe the nature of the therapeutic relationship commonly
found in CAM. In many ways it could be considered to reflect some of the key drivers of
the CAM renaissance described above. In its most developed form, the relationship itself
can be intrinsically beneficial and may become a catalyst for self-healing. However,
expectations of the therapeutic relationship vary within and among cultures, locations,
user groups and demographics. This book explores many of the problems associated with
attempts to research and evaluate therapeutic relationships. The paradox remains that,
although CAM is becoming increasingly popular and there are increasing numbers of
personal testimonies to its effectiveness, firm ‘scientific’ proof that the interventions
work remains elusive.
Complementary and alternative forms of health care are not the exclusive domain of
contemporary British society. This book takes a wider look at traditional as well as folk
forms of health care, with the aim of shedding light on current CAM practice in the West.
This immediately exposes the fluid nature of CAM definitions and practice: some
modalities and practices that were sited within folk practice, and were often transposed
from diverse cultures, have developed into current CAM practice. Also, the redefinitions
are not entirely one-way: some previously established orthodox medical practices have
become marginalised and now are either abandoned or considered to be CAM. In a
similar vein, certain traditional medical practices originating from developing countries
have crossed the barrier and become accepted into orthodox western medical practice.
This is particularly true of the use of certain herbal products. Examples are given in this
book of the commercial exploitation of traditional herbal remedies. In some cases the
indigenous peoples who first understood the healing properties of particular biologically
available remedies cannot now afford the commercially developed products derived from
‘their’ locally grown products.
This book explores ways of finding out about the patterns of contemporary CAM use.
Using expertise from a geographical knowledge base, this book demonstrates how the
growth and spread of CAM use can be charted. CAM developments often reflect changes
within secular society (Doel and Segrott, 2003), which is apparent from the types of
people who are motivated to become CAM practitioners. For example, Andrews (2003)
has researched the large numbers of nurses who have left the NHS, often because their
ability to provide satisfactory standards of care within the formal system was constrained.
The world of CAM, by contrast, has enabled them to provide individualised and often
intensive care for people in need. All too often people in need of the services of a CAM
practitioner have to find the money to pay for their attention. The complex ‘cash nexus’
within the world of CAM is explored in this book. Although CAM has become a large
consumer industry, evidently many CAM practitioners continue to provide services at the
level of a cottage industry. Often the small-scale practitioners and private therapists
struggle to make a living from their new vocation. There may also be tensions between
working as a CAM therapist and the business of running a small private enterprise.
However, many large companies are not similarly constrained and there is evidence of
considerable profitability in marketing CAM products and services to the wider public.
One way of avoiding the problems of market forces potentially contaminating the
delivery of CAM services would be to incorporate more CAM within the NHS. This
possibility is explored and some of the problems of, as well as the considerable potential
for, this ‘integrated’ development are discussed. Although there are many examples of
the successful integration of CAM developments in the NHS, several problems remain,
and the continued development of integrated medicine is not supported by central
government policy directives or by mainstream NHS funding.
The final part of this book explores some of the information sources that are available
to help members of the general public access the changing world of CAM. Which
therapies should they use for specific problems? How can they check whether the
information sources are accurate and reliable? Here again the user is faced with a
changing and potentially perplexing plethora of sources of information. The world of
CAM cannot be simply delineated, and the multiple sources of available information
reflect this diversity and rapidly changing and expanding milieu. However, in this part, as
in the rest of the book, you will find ways to understand and interpret changing
perspectives that can be used to further your understanding of this exciting subject area.
Tom Heller and Sue Spurr, The Open University, September 2004
References
Andrews, G. (2003) ‘Nurses who left the British NHS for private complementary medical practice:
why did they leave? Would they return?’, Journal of Advanced Nursing, Vol. 41, No. 4, pp.
403–15.
Bakx, K. (1991) ‘The “eclipse” of folk medicine in western society’, Sociology of Health and
Illness, Vol. 13, pp. 20–38.
British Medical Association (BMA) (1993) Complementary Medicine: New Approaches to Good
Practice, London, BMA.
Cant, S. and Sharma, U. (1999) A New Medical Pluralism? Alternative Medicine, Doctors, Patients
and the State, London, UCL Press.
Doel, M. and Segrott, J. (2003) ‘Beyond belief? Consumer culture, complementary medicine, and
the dis-ease of everyday life,’ Society and Space, Vol. 21, pp. 739–59.
Gabe, J., Kelleher, D. and Williams, G. (eds) (1994) Challenging Medicine, London, Routledge.
Giddens, A, (1991) Modernity and Self-Identity. Self and Society in the Late Modern Age,
Cambridge, Polity Press.
Saks, M. (1992) ‘Introduction’, in Saks, M. (ed.) Alternative Medicine in Britain, Oxford,
Clarendon Press.
Sharma, U. (1992) Complementary Medicine Today: Practitioners and Patients, London,
Routledge.
Thomas, K., Carr, J., Westlake, L. and Williams, B. (1991) ‘Use of non orthodox and conventional
health care in Great Britain’, British Medical Journal, Vol. 302, 26 January, pp. 207–10.
1
Complementary and
Alternative Medicine in
Context
Edited by Jeanne Katz and Geraldine Lee-Treweek
Chapter 1
Changing perspectives
Geraldine Lee-Treweek
AIMS
■ To show how complementary and alternative medicine is evolving as part of the
process of social change in which there are competing sets of knowledge, diverse
lifestyles, more choice for some members of society and a rise in consumerism.
■ To contextualise complementary and alternative medicine in the western health care
system in terms of changing patterns and challenges to the dominance of medical
knowledge and ideology.
1.1 Introduction
Contemporary society is continuously changing and increasingly complex. Along with
this change there is also greater choice about lifestyle and belief At the same time, many
sets of knowledge and ideas about the world coexist and compete for attention—different
accounts of how things are. This is the case with choice and knowledge about health,
illness and wellbeing. Complementary and alternative medicine (CAM) offers a vast
array of choices in dealing with issues of health and wellbeing. This chapter invites you
to consider CAM in a critical way and to see what it can offer to society. It outlines some
of the debates and issues that highlight the social changes, which include popular interest
in CAM.
The chapter begins by introducing CAM as a fascinating and fast-changing area of
social life. It also discusses the concepts that are often seen as underpinning CAM and
some of the assumptions people make about what it involves. It highlights the debates
within CAM about how these forms of treatment and therapies should be defined and
understood. In many ways the issue of what CAM is can be considered contentious and
open to debate. You will be encouraged to engage with such debates and reach a view
about how you understand such contentious issues.
This chapter goes on to contextualise CAM as part of much broader changes in
modern western society. To understand CAM in contemporary society, the social trends
and structures that allow it to flourish and grow must be considered. In particular, the
chapter discusses where differing opinions, or world views, of health and healing come
from and why increasing numbers of people want to use different types of therapy. It is
also useful to consider why the number of people offering CAM in the UK has grown so
much since the 1980s. These new ‘experts’ on health and wellbeing are highly visible in
the media, on the high street and even in people’s bathroom cabinets (in the
complementary therapy products they buy to treat themselves). In the last 100 years,
priorities in life and expectations of health have changed dramatically, as have people’s
ideas about appropriate ways of managing illness and lack of wellbeing. This chapter will
involve drawing on your own experience to examine how you see your health and think
about the impact of CAM on society.
The chapter title highlights changing perspectives. Change also incorporates a
struggle between different paradigms as well as competition. There is competition
between and among a variety of groups: between CAM and orthodox medicine, but just
as likely between different types of CAM. Issues of power, knowledge and change
permeate the contemporary study of CAM. Indeed, the diversity within CAM makes it
such an interesting topic. As well as considering this issue, the focus is on various
integrations and collaborations. That is to say, the emphasis here is on the way in which
not only is CAM continually developing but also some people who, at first sight, might
be expected to be negative towards it. In particular, not only are the medical profession
and members of professions allied to medicine moving towards greater acceptance but
also many medically qualified practitioners are now training in CAM as an adjunct to
their orthodox skills (Zollman and Vickers, 1999).
1.2 Defining complementary and alternative medicine (CAM)
The term ‘complementary and alternative medicine’ (CAM) is used in a variety of places:
pharmacies, local newspapers, Yellow Pages, television and radio, general practices, the
high street, complementary health clinics, etc. As with many other terms, CAM has
different meanings for different people. Most people have assumptions about what the
term means and, from these assumptions, expectations about what CAM can offer in
terms of treatment. Sometimes such assumptions can lead people to overestimate or
underestimate a particular CAM: viewing it with suspicion or open acceptance. To
understand this subject you need to examine your own assumptions and consider how
they might affect your views of CAM and whether you choose to use it.
‘USERS’, ‘PATIENTS’ AND ‘CLIENTS’: A NOTE ON TERMINOLOGY
In this chapter the term ‘user’ refers to people who use CAM. In many CAM disciplines
you will hear different terms for the service user. For instance, you may read or hear the
terms ‘patient’ or ‘client’ in leaflets about different forms of CAM, on websites, or when
practitioners discuss their work. Here ‘user’ is the most common term. However, when a
specific CAM is discussed, the term chosen will be the one most often used by
practitioners in that field. In this way, the term used in this text will always be the most
authentic to that particular CAM discipline.
ACTIVITY WHAT ARE YOUR ASSUMPTIONS ABOUT CAM?
Allow 10 minutes
Perspectives on complementary and alternative medicine 4
List five words you associate with CAM and what it is about. You may not have much
personal experience of CAM, in which case list terms you have seen in the media or
heard friends or family use.
Comment
There is a range of words and ideas you might associate with complementary and
alternative medicine, including natural, mumbo jumbo, weird, relaxing, hippy, healthy,
unscientific and traditional. Certainly a diversity of words spring to mind when thinking
about CAM! Quite often they depend on people’s personal experience of the area or the
information gathered from friends, relatives and the media.
Commentators with a variety of perspectives on CAM have tried to identify what key
concepts can be associated with it. For instance, Anthony Campbell, a consultant
physician at the Royal London Homoeopathic Hospital, argues that there are four
assumptions underpinning many CAMs (Campbell, 2002, pp. 3–12).
CAM as natural
Campbell (2002, p. 3) notes that the idea of particular forms of medicine or health care
being natural is a fairly new concept that developed and gained strength during the 20th
century. Nowadays the concept relates not just to the idea of particular remedies or
treatments as being ‘more natural’ than pharmaceutical or orthodox ones but also to the
growing social idea that the body heals naturally. The human body is seen as having a
natural ability to repair itself and so CAM is there to help this process along.
CAM as traditional
CAM medicines are often claimed to have a long history of healing or links and
connections with allegedly older ideas of medicine and health. Some forms of CAM,
such as traditional Chinese medicine (TCM) demonstrate a heritage of healing going back
thousands of years. Campbell (2002, p. 6) draws attention to how tradition and the appeal
to the idea of tradition is often a key feature of many types of CAM. Thinking critically
about the use of the term ‘traditional’ in relation to health practices raises important
questions. Just because something is ‘traditional’, does that necessarily mean it is safe or
effective? Are treatments from the past or with a long history better than newer
treatments? The term ‘traditional’, while used to justify some types of CAM, does not
really help to answer such questions.
CAM as holistic
There is a widespread view that different types of CAM (or modalities) try to understand
illness in the context of the whole person (Campbell, 2002, p. 7). That is, a person is not
just a physical body but can be seen as having several levels—mind, body and spirit—
which need to be considered together to understand and treat illness and disease. Many
CAM practitioners believe that consultations should include more time to discuss with an
Changing perspectives 5
individual not only health and illness but also how they feel ‘in themselves’, their
background, and their emotions and thoughts. Holistic treatment tries to tailor the whole
treatment experience to suit the user as a unique person. Another way of understanding
this is to consider the opposite of holism, which is reductionism. A reductionist approach
sees illness and disease as being associated with a particular part of the body—in the cells
of the body for instance—and deals with that problem without considering the needs of
the whole person with the ailment. Modern orthodox medicine is often said to take a
reductionist view of health and illness, treating only the diseased part and taking less
interest in the individual as a whole. This way of viewing medicine, although
undoubtedly true in some settings, is a generalisation that ignores the way in which many
aspects of medicine are moving towards being more holistic and person-centred.
CAM as energy
CAM often refers in some way to the notion of energy. Campbell (2002, p. 11) maintains
that the idea of people having a vital force or energy is shared by many CAMs. This often
relates to energy flowing around the body in a particular pattern. Different therapies use
different names for energy: you may hear the terms qi, chi, prana or life force, depending
on the type of practitioner Many CAM practitioners see at least part of their role as
getting energy moving properly around the body, helping to remove blockage, or
rebalancing problems in the energy field. Normal flowing energy is usually considered a
prerequisite to health as, allegedly, the body can heal itself better if energy moves
through it correctly.
Other ideas about the features of CAM
Campbell (2002) discusses what he views as the key assumptions of CAM. However,
other people emphasise very different features or identify more differences than
similarities between CAMs (Sharma, 1992). For instance, it could be argued that the way
the practitioner treats the user varies across the different CAMs. Hypnotherapy involves
using deep states of relaxation or trance to attempt to modify users’ behaviour. The
practitioner’s role is to facilitate the trance state and, allegedly, to use suggestion to help
the user attain their goal, such as to stop smoking or to be more confident. Here the
practitioner often sees the user only two or three times. In other CAMs, such as massage,
the user may return for treatments repeatedly. Clearly, the practitioner’s role is different
in such CAMs: they involve different styles of treatment—touching the body and talking.
It is important to recognise that, as well as key similarities between CAMs, distinctions
can also be drawn between different ones by focusing on aspects of treatment and
approach.
Challenging assumptions
Given the assumptions people make about CAM, it is important to establish a set way of
using the term in this book. It will become apparent that different groups, individual
writers and organisations have a preference for (and tend to use) the terms ‘alternative’ or
‘complementary’. For instance, ‘alternative’ implies separation or a complete difference
Perspectives on complementary and alternative medicine 6
from other types of medicine, whereas ‘complementary’ suggests working alongside or
with other types of medicine. Some commentators, such as Sharma (1992), argue that
CAM represents such a broad range of practices that have so little in common with one
another that it is very difficult to talk of them as a whole. In this book CAM means forms
of health care and treatment that are commonly regarded as non-conventional at present.
This does not mean some CAMs will not be, and indeed are not being, integrated into
more orthodox health settings and services. The definition and understanding of CAM
used here focuses on how particular therapies or medicines are regarded by the majority
of people.
There are many non-conventional types of medicine. The most common ones are:
■ Osteopathy and chiropractic—the ‘hands-on’ treatment and manipulation of the
muscular and skeletal system.
■ Homoeopathy—the treatment of illness with very small doses of medicines. The
medicine used is chosen because it can cause the symptoms being treated if taken in
larger doses.
■ Medical herbalism—the use of herbal preparations to aid the individual.
■ Acupuncture—the insertion of needles into the body to treat a range of problems.
These types of CAM are often collectively referred to as the ‘Big Five’ because of their
popularity and high levels of usage (House of Lords Committee, 2000). However, there
are many other types of CAM, which are introduced and explained briefly in Section 1.3.
It is important to note that a type of medicine or treatment considered to be a CAM
today may become an accepted mainstream treatment tomorrow. In the field of CAM
there is a high level of change, which is one reason why it is so interesting to study. There
are changes in the public acceptance and use of CAM, and how the medical profession
perceives it, in terms of regulation, in the types of training involved, and in the patterns of
integration of CAM into conventional health care settings. Such change makes
categorising CAM more challenging. It is worth noting here that people working in a
particular CAM often find their work categorised by others—the media, groups within
orthodox health care, other CAM organisations, etc.—in ways that run counter to how
they see themselves. In Chapter 2 the difficulty of trying to categorise CAM is examined
in more detail, along with the broader debates around using the terms ‘alternative’ or
‘complementary’. Throughout this book it is important to remember that CAM is a highly
contested field, in which there are often disputes and disagreements about what it is and
its efficacy and role in contemporary society.
Why study CAM and why now?
Clearly, CAM is a contentious area. Its rapid change is enough to make it a fascinating
area for scholarly investigation. However, some other issues also make it important to
study this area.
■ CAM is increasingly popular and more people use it today than in the recent past.
Estimates suggest that in the UK between 6.6 per cent and 2 per cent of the population
use CAM (Ong and Banks, 2003, p. 23). A study by Thomas et al. (2001) showed that
people who consulted CAM practitioners for six of the most established CAMs rose
from 8.5 per cent of the population of England in 1993 to 10.6 per cent by 1998. This
Changing perspectives 7
may be an underestimate as it does not include the use of some ‘less established’
CAMs.
■ People are choosing to buy CAM products over the counter at a range of outlets—from
high street retail stores to health food shops and over the internet. Statistics from
Mintel (2003) show that £130 million was spent in the UK in 2002, the prediction
being that the CAM market will be worth £200 million by 2008. This includes sales of
such products as herbal remedies, homoeopathic preparations and aromatherapy oils.
■ The rise in public interest in CAM is mirrored by a rise in the interest of medicine,
nursing and professions allied to medicine. In particular, orthodox health services now
increasingly integrate CAM as part of their range of services (Zollman and Vickers,
1999).
ACTIVITY THE CONSEQUENCES OF GREATER CAM USE
Allow 5 minutes
Think about the reasons why, and for whom, it might be important to know that people
are increasingly using CAM for health and wellbeing.
Comment
The greater use of and interest in using CAM has consequences in terms of provision.
CAM organisations need to know whether more training is necessary to meet public
needs. As public interest grows, public pressure will also grow for health services to offer
more CAM in hospitals, primary care services and other settings. Information about
growing public demand will be needed for planning and organising such services. There
are important issues around the safety of CAM and its efficacy (whether it works or
produces the desired effect). People use CAM in their homes, as well as seeing
practitioners, so it is important to know what they are self-treating and how they use the
products, as well as being sure that the products work and are safe. Therefore, the
different groups of people who might want information about the move towards the
greater use of CAM include: health policy makers, hospital and primary care managers,
doctors or members of the allied health professions and retail managers (who may like to
know whether people want to buy aromatherapy oils in their stores, etc.).
CAM offers a range of services in the contemporary health marketplace. However, while
there is more choice, there is also more need to ensure that people using CAM can make
an informed choice, including the aspect of safety, about the services and products
available. CAM can be seen as part of a wider move towards more choice in what can be
bought, and indeed in what people want to buy, in contemporary society. It is important
to understand the context in which CAM has become popular: the changes in general
society that provide the context to the choices that CAM offers.
Perspectives on complementary and alternative medicine 8
1.3 Living in a complex and diverse society
Many people, including social scientists, believe that UK society is complex and diverse
(for example, Andersen and Taylor, 2003). Certainly, life experiences seem to have
become increasingly diverse and often geographically wide ranging, including the
following areas.
■ Where people live. People are now more prepared (and indeed may have no choice) to
move long distances for work, or for other commitments, and they may do this several
times in their lives.
■ Where people work and what they do. There is a trend towards regular occupational
change: people do not generally stay in the same job for life and often retrain in a
completely different field.
■ People’s tastes, interests and lifestyles. Today people are more likely than in the past
to combine diverse and unusual pastimes and interests. These tastes are influenced by
factors such as family background, places visited, television and other media.
■ People’s choice of health care and products that enhance their wellbeing. The
range of people offering their services in the fields of health and wellbeing is diverse
and there is a greater choice for users. This means there is a wider choice of health
providers for individuals to choose from, as long as they can afford the treatment.
Some people also buy over-the-counter health treatments, such as herbal remedies or
aromatherapy oils, while simultaneously taking prescription medications from their
GP and continuing to attend a National Health Service hospital.
Social trends indicate that people’s lives in the UK have radically altered over the last
100 years, bringing a range of choice in many aspects of life. In other words, the mixing
and matching of different ideas, activities and experiences is a feature of everyone’s
lives, to an extent, in a complex society.
ACTIVITY HOW DOES DIVERSITY AFFECT YOUR LIFE?
Allow 15 minutes
Spend 15 minutes thinking about your life, interests and tastes. Write a list of your
interests and tastes in food. Are there any apparent contradictions or examples of
diversity in your list?
Comment
You may have noted that you combine many ideas to inform even your food tastes.
For instance, because of access to both products and creative ideas about food, it is quite
common for people to have Italian-inspired meals one day, curry the next, and vegetarian
food the day after. The same applies to other aspects of life because, in contemporary
society, so much is on offer that people can ‘pick and mix’ their approaches to any
particular facet of their lives, which includes the choices made about health and illness.
Changing perspectives 9
The characteristics of a complex society
On a personal level, most people can identify with the ‘pick and mix’ approach to modern
social life in their own lives. Social scientists have tried to go beyond these personal
understandings to capture the key features of modern life and how people have become
accustomed to diversity and change. To understand this it is necessary to outline the
general patterns of change in recent history. The period after the industrial revolution in
the 18th century is often referred to as ‘modernity’. The industrial revolution seemed to
bring endless possibilities for society, especially in the fields of science, medicine,
technology and governance. At the same time, these areas of knowledge and
understanding took a dominant and authoritative position in explaining and describing the
world. So, taking science as an example of a key dominant set of knowledge, it can be
seen that a scientific explanation is believed to be more legitimate in explaining events
and phenomena than other types of knowledge. Lay knowledge, or the understandings
and theories of the man or woman in the street, has generally been considered less useful
than that of scientists, who test their knowledge with scientific methods. There is what
can be termed ‘a hierarchy of knowledge’: that is, different knowledges are ranked, some
being seen as having credibility and veracity and others being seen as less likely to be
accurate or correct. Modernity can thus be viewed as a period in which certain sets of
knowledge became well established as the way of understanding the world.
It may strike you that people do not trust science as much as they did. There are many
examples of lay people refusing to accept or challenging the knowledge of science on the
basis of their own knowledge, experiences or feelings. One example is parents who will
not accept medical orthodoxy about immunisation (in particular the MMR—measles,
mumps and rubella—vaccine) and openly challenge both scientific accounts and social
policy by not having their children immunised (Heller et al., 2001). Commentators on
social change in the West note that societies seem to have gone through another stage
since modernity, which they call ‘post-modernity’ (Lyotard, 1984; Sarup, 1993). Whereas
modernity was epitomised by the development of sets of knowledge which claimed to be
the ways of understanding the world, in post-modernity this certainty is replaced with
doubt and questions. The sets of knowledge that described the world became less
powerful (Sarup, 1993). Several other key features are identified as part of post-
modernity, including the following.
■ A change towards a society driven by information technology, in which new forms of
technology have changed both the nature of work and other aspects of life. At the
same time, industries such as shipbuilding and steel production are in decline and new
forms of work demand skills related to information technology.
■ A mixing and matching of ideas that perhaps would not have been combined in the
past.
■ A growth in the area of consumer culture and consumption. The term ‘consumption’
relates to the goods and services individuals choose to buy and use.
■ A ‘pick and mix’ approach to life. In particular, the tendency for people to engage in a
wide range of leisure, work and social pursuits.
If modernity can be characterised by the development of sets of knowledge which sought
to develop authority in explaining and describing the world, post-modernity can be
characterised by the break-up of these large sets of knowledge (Lyotard, 1984). Put
Perspectives on complementary and alternative medicine 10
another way, in post-modernity people no longer tend to believe there is one authority on
a topic. The ‘professional’ (doctor, lawyer, scientist, etc.) is no longer seen as having all
the answers and always being right—an attitude that opens such types of knowledge to
criticism and challenge.
The influence of Anthony Giddens
Anthony Giddens’ highly influential
work focused on describing and
explaining social change in western
societies
The ideas about social change of the eminent sociologist Anthony Giddens have been
very influential in the social sciences and the humanities. He describes more recent
modern life (within the last 30 years or so) as ‘late modernity’ (Giddens, 1990). He uses
this term rather than ‘post-modernity’ because, he argues, if something is ‘post’ it
suggests a complete change. He sees the processes of modernity and late modernity as
merging together and so does not use the term ‘post-modernism’. However, he writes
about very similar changes in society to those suggested by his post-modernist
contemporaries. Giddens (1990) adds other dimensions to the discussion of the features
of present-day society that is of interest when discussing CAM:
■ The rise of new groups of people who present themselves as ‘experts’ on particular
topics, such as how to be healthy or what to do when they are ill.
■ Despite disputes within academic discussion about terminology, there is general
agreement that there has been a move away from believing in a set hierarchy of
knowledge and a greater acceptance of a wider range of sets of knowledge, ideas and
‘experts’ within society.
Changing perspectives 11